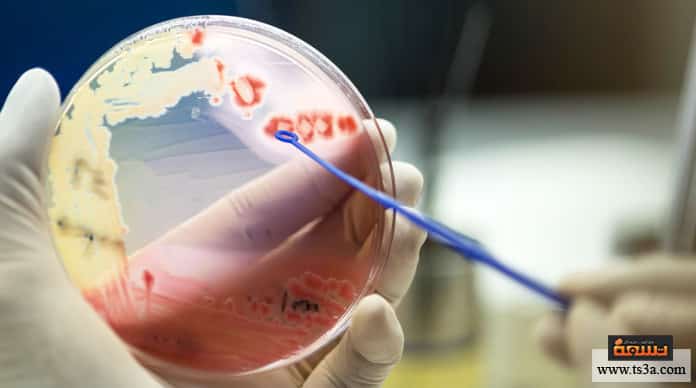
d8a7d984d8aad987d8a7d8a8-d8a7d984d8b3d8add8a7d98ad8a7-d8a7d984d8a8d983d8aad98ad8b1d98a-d8a3d8b9d8b1d8a7d8b6-d8a7d984d8aad987d8a7d8a8-d8a7d984d8b3d8add8a7d98ad8a7-d8a7d984d8a8d983d8aad98ad8b1d98a التهاب السحايا البكتيري أعراض التهاب السحايا البكتيري

كيف تقي نفسك من التهاب السحايا البكتيري بطرق بسيطة؟
تعد أمراض المخ والأعصاب لا سيما مرض التهاب السحايا البكتيري هي الأبرز والأشهر في الآونة الأخيرة في ظل ذاك التلوث الحادث على الساحة في شتى المجالات، ولا شك أن التهاب السحايا البكتيري هو مرض مرعب نظرًا لخطورته وقدرته الشديدة على تدمير صحة الإنسان.
Share your love
يعاني عشرات الآلاف حول العالم من مرض غريب وخطير جدا يسمى مرض التهاب السحايا البكتيري وهو عبارة عن التهاب حاد ومضر جدا في الأغشية الواقية التي تغلف أجزاء الدماغ والنخاع الشوكي، وهذه الأغشية هي ما تُعْرَف باسم السحايا، وهذه الالتهابات قد تتطور وتنتقل للخلايا المجاورة وتسبب مضاعفات خطيرة بالدماغ والحواس.
وهناك عدة أسباب تؤدي إلى التهاب السحايا البكتيري فقد تكون عدوى فيروسية أو عدوى بكتيرية أو غير ذلك من الكائنات الدقيقة التي تتسبب في التهاب السحايا، كما أن الأدوية والعلاجات الطبية المختلفة تتسبب كثيرًا أيضًا في التهاب السحايا البكتيري الذي يمثل خطرًا كبيرًا على الحياة بسبب قربه من المخ والحبل الشوكي؛ الأمر الذي يجعله حالة طارئة تستوجب الاهتمام السريع ومحاولة فحص الأنسجة والتي تتم عبر عمليات البزل وسحب عينة من السائل في القناة النخاعية ثم يتم فحصها في مختبرات طبية خاصة ومحاولة إسعافها بالمضادات الحيوية في أسرع وقت ممكن مع حقن الجسم بمضادات فيروسية وفطرية للتغلب على تلك الالتهابات.
التهاب السحايا البكتيري عند حديثي الولادة

قد يتعرض الأطفال حديثي الولادة للإصابة بمرض التهاب السحايا البكتيري منذ الولادة وحتى سن الثلاث سنوات، وتكون البكتيريا والجراثيم الأكثر سببًا في إصابتهم هي ما يسمى بالعقديات وخاصة مع تلوث الهواء وارتفاع درجات الحرارة، وهذه العقديات هي المسؤول الأول عند إصابة الأطفال حديثي الولادة بالتهاب السحايا البكتيري خلال الأسبوع الأول من الحياة، وكذلك تتسبب الجراثيم المنتشرة في البطن وتحديدًا في أعضاء الجهاز الهضمي مثل الإشريكية القولونية، ومن البكتيريا التي تصيب الأطفال بالتهاب السحايا البكتيري كذلك نجد الليستريا المولدة للوحيدات وقد ينتج عنها أوبئة.
التهاب السحايا البكتيري عند الأطفال
عندما يصاب الأطفال بعد سن الخامسة بمرض التهاب السحايا البكتيري فإنهم غالبا يعانون من كثرة تفشي جراثيم النيسرية السحائية في الجسم، وهذه النيسرية السحائية ما يطلق عليها أيضًا اسم المكوّرات السحائية والعقدية الرئوية، وأما أولئك الأطفال الذين يصابون بمرض التهاب السحايا البكتيري وهم أقل من الخمس سنوات فإن أجسامهم صابون تكون مصابة بما يسمى المستدمية النزلية، وهناك دول عديدة تقدم تطعيمات من مثل تلك الأمراض، ودول أخرى لا تقدم ذلك أية تطعيمات وبالتالي شعوبها تمثل نسبة كبيرة من فئة المصابين بالتهاب السحايا البكتيري حول العالم، وعلى كل حال يجب الانتباه بصحة أطفالنا وضمان حمايتهم من الاصطدام بالرأس أو زيارة مريض بدون وسائل وقائية حتى لا يصابون بالتهاب السحايا البكتيري.
التهاب السحايا البكتيري عند الكبار
عندما يصاب الكبار والبالغين بمرض التهاب السحايا البكتيري فإنهم يتعرضون لبكتيريا وجراثيم تحت اسم النيسرية السحائية والمكورات العقدية الرئوية وهذه الكائنات تتسبب في أكثر من80 بالمائة من حالات التهاب السحايا البكتيري والجرثومي، عند الكبار والبالغين كذلك يزداد خطر ونسبة إصابتهم بالتهاب السحايا البكتيري إذا أصيبت أجسامهم بالليستريا المولدة للوحيدات وخاصةً في أولئك الأشخاص الذين تتجاوز أعمارهم الخمسين عامًا.
أسباب التهاب السحايا البكتيري
هناك مسببات عديدة تصيب الجسم بمرض التهاب السحايا البكتيري والتي في الغالب تأتي عن طريق العدوى ببعض البكتيريا والجراثيم والكائنات الحية الدقيقة، وفي معظم الأحيان تكون الفيروسات هي المسبب الرئيسي لذلك، ويليها البكتيريا والفطريات والطفيليات التي تصيب منطقة السحايا، وفي أحيان أخرى يحدث ذلك المرض بدون أية عدوى، وفيما يلي نوضح تلك المسببات المرضية بشيء من التفصيل:
مسببات بكتيرية
وفي هذا النوع من إصابات السحايا تتنوع البكتيريا التي تسبب التهاب السحايا ويكون ذلك وفق عمر المصاب، فقد يكون التهاب سحايا سلي، أو التهاب سحايا ناتج عن بعض الكائنات البكتيرية المتفطرة السلية، وهذا مبرر لانتشار مرض السل في بعض البلدان التي تنتشر بها هذه الأنواع من البكتيريا التي قد تصيب أيضًا الكثير من الأشخاص الذين يعانون من المشكلات المناعية المختلفة مثل الإيدز.
مسببات الفيروسية
قد تتسبب الفيروسات كذلك في انتشار مرض التهاب السحايا البكتيري وتلك الفيروسات تتنوع فيما بينها لتشمل الفيروسات المعوية وهي أقل شيوعًا في كمسببات للمرض، وفيروسات الحلأ أو ما يسمى فيروس الهربس البسيط وهي الفيروسات الأكثر شيوعًا كمسبب للمرض وتتسبب كذلك في معظم القروح التناسلية، وأيضًا من الفيروسات المسببة لمرض التهاب السحايا البكتيري نجد فيروس الحماق النطاقي والذي يتسبب في الإصابة بمرض الجديري والهربس النطاقي، بالإضافة لعدة فيروسات أخرى مثل فيروس النكاف، وفيروس نقص المناعة البشرية، وفيروس التهاب السحايا والمشيميات اللمفاوية.
مسببات فطرية
عندما تتسبب الفطريات في الإصابة بمرض التهاب السحايا البكتيري فإن الجسم يكون عرضة لبعض المخاطر التي قد تودي بالحياة أو بظهور أمراض تابعة وخاصة عندما يصاب الجسم بهذه الفطريات في الوقت الذي يتناول فيه أدوية مثبطة للمناعة، أو أن يصاب في التوقيت ذاته بفيروس الإيدز وهو نقص المناعة البشرية أو أن يصاب الجسم فقدان المناعة عند مرحلة الشيخوخة، وهذا يبرز لنا كم أن نقص المناعة يعتبر بيئة صحية سليمة للإصابة بفطريات التهاب السحايا، بينما يكون من غير الطبيعي أن يصاب بها من يتمتعون بنظام مناعة طبيعي.
مسببات طفيلية
عندما تكثر بعض خلايا الدم البيضاء المعروفة بالحمضات في السائل النخاعي الشوكي، فإن الجسم يكون في عرضة للإصابة بمرض التهاب السحايا وذلك عبر انتشار الطفيليات في الجسم، كما أن من الطفيليات الأكثر تسببًا في الإصابة بمرض التهاب السحايا نجد دودة الأسطوانية الكنتونية، وما يسمى بالفغمية المقنفذة، وكذلك البلهارسيا، وبعض الأمراض مثل داء الكيسات المذنبة، وداء السهميات، وجانبية المناسل، وبعض الإنتانات وغير الإنتانات.
مسببات غير معدية
هناك مسبت غير معدية قد تؤدي للإصابة بالتهاب السحايا وذلك كأن تنتشر الخلايا السرطانية بمنطقة السحايا، وعندها يسمى التهاب السحايا الورمي أو الالتهاب الخبيث، كما قد تتسبب بعض الأدوية في إصابة الدماغ بمرض التهاب السحايا البكتيري وذلك مثل تناول مضادات الالتهاب غير الستيرويدية وتناول المضادات الحيوية والغلوبولينات المناعية الوريدية، كما قد يكون السبب في التهابات السحايا غير المعدية، وبالإضافة لكل ما سبق فإن من المسببات الغير معدية التي قد تصيب الجسم بالتهاب السحايا ما يلي: الساركويد أو الغرناوية العصبية، واضطرابات الأنسجة الضامة كالذئبة الحمامية، وكذلك التهابات الأوعية الدموية، وأمراض الكيسة البشرانية والكيسة الجلدانية التان قد تتسبب في التهاب السحايا وأخيرًا قد يتسبب الصداع النصفي في التهاب السحايا.
مسببات تشريحية
أثبتت الدراسات أن التهاب السحايا البكتيري قد يصيب الجسم كذلك ولكن عبر مسببات أخرى غير البكتيريا والفيروسات والجراثيم والطفيليات، ومن تلك المسببات نجد العيوب التشريحية في الدماغ سواءً كانت خلقية أو مكتسبة، أو ناتجة عن اضطرابات في الجهاز المناعي للجسم؛ فهذه العيوب التشريحية تؤدي لحدوث خلل في الجهاز العصبي.
كما أن من المسببات التشريحية لإصابة الجسم بالتهابات السحايا أن تتعرض الجمجمة لكسور تؤثر في قاعدتها وربما تمتد إلى منطقة الجيوب الأنفية أو العظم الصدغي، ورغم أن هذه المسبات التشريحية غير متأثرة ببكتيريا أو كائنات دقيقة ضارة إلا أنها تتسبب في إصابة حوالي59 بالمائة من حالات التهاب السحايا المتكررة حول العالم، بينما حوالي 36 بالمائة من حالات الإصابة بالتهابات السحايا يكون ناتجًا عن نقص المناعة، بينما 5 بالمائة تكون ناتجة عن انتقال العدوى من المناطق المنتشر فيها أمراض السحايا.
مضاعفات التهاب السحايا

في كثير من الأحيان ما يترتب على الإصابة بالتهاب السحايا تطورات ومضاعفات خطيرة قد تودي بحياة المصاب، فقد يحدث أن يتطور الطفح الحبري ويتحول إلى غرغرينا تتسبب في بتر أطراف الحالات المصابة تلك، ولكن في معظم الأوقات بعد البتر ينجو المريض بحياته.
وفي أحايين أخرى قد يتطور المرض وتحدث له مضاعفات عدة تتمثل في هبوط شديد في ضغط الدم مع سرعة كبيرة في دقات القلب مع ملاحظة ارتفاع أو انخفاض كبير وبشكل غير طبيعي في درجة حرارة الجسم يعقبه سرعة في التنفس بشكل كبير.
في أوقات أخرى من مضاعفات التهاب السحايا البكتيرية قد يتعرض الجسم لانخفاض حاد في ضغط الدم مما قد يحول دون كفاية باقي الأعضاء من إمدادات الدم، ومع الوقت قد تحدث غرغرينا أو يصاب الجسم ببعض التلازمات المرضية التي تودي بحياته.
في مراحل أخرى من المرض ومضاعفاته قد تتعرض أنسجة الجسم للانتفاخ، وكذا يرتفع الضغط داخل الجمجمة والدماغ بشكل كبير للغاية ما يترتب عليه انخفاض الوعي عند المريض وتعرضه لأوضاع غير طبيعية وتغير شكل حدقة العين؛ الأمر الذي بتطوره قد يمنع تدفق السائل النخاعي الشوكي حول الدماغ ويحدث ما يسمى بالاستسقاء الدماغي؛ ويترتب على كل ذلك العديد من النوبات الاختلاجية الثابتة والبؤرية والتي تؤدي مع الأدوية على المدى الطويل إلى الوفاة.
ومن مضاعفات التهاب السحايا البكتيري كذلك أن تضطرب الأعصاب القحفية، وهي عبارة عن أعصاب تنشأ من جذع الدماغ وتمر خلال الرأس والرقبة وتتحكم في حركة العينين، وعضلات الوجه، والسمع؛ وأي أضرار صحية فيها قد يفقد الإنسان بصره أو سمعه أو يفقد الإحساس أو أي من وظائف تلك الأعصاب القحفية.
هل يمكن الشفاء من التهاب السحايا؟
رغم أن التهاب السحايا البكتيري من الأمراض الصعبة للغاية والتي تضر الجسم بشكل كبير وقد تؤدي إلى وفاته، إلا أن العلم استطاع الكشف عن بعض العلاجات المفيدة في تلك الحالات مثل:
العلاج بالمضادات الحيوية
تعتبر المضادات الحيوية من أفضل الأدوية لعلاج التهاب السحايا البكتيري، كما يستخدم بكثافة في الوقاية والحماية لأولئك المرافقين لمرضى التهاب السحائيات، ومن أبرز تلك المضادات الحيوية المستخدمة نجد ريفامبيسين، سيبروفلوكساسين، سيفترياكسون، ورغم أنها مضادات تقي من الإصابة بالمرض إلا أنها غير قادرة على الوقاية من خطر العدوى في المستقبل.
العلاج بالستيرويدات
يمكن علاج حالات التهاب السحايا البكتيري عبر اللجوء للستيرويدات القشرية ويكون لها فوائد إيجابية كبيرة في التقليل من آثار التهابات السحايا على الحواس المختلفة كالسمع والبصر على سبيل المثال، كما أن الستيرويدات القشرية تحدث نتائج عصبية قصيرة المدى مفيدة للغاية لفئة المراهقين والبالغين على السواء، وهذه الستيرويدات لا تفيد فقط في علاج حالات التهاب السحايا البكتيري، بل إن فوائدها تتعدى ذلك لتسهم في تقليل نسب وفيات مصابي الإيدز
تعتبر الستيرويدات القشرية من المواد الهامة لعلاج التهابات السحايا البكتيرية وتختلف أهميتها من حالة لأخرى وفق عمرها سواء أطفال أو بالغين، وفي الغالب نجدها تنتشر كثيرًا لدى الدول المتقدمة الغنية، بينما يصعب توفيرها في تلك الدول متدنية الدخل، وفي كل الأحوال يجب الالتزام بإعطائها للمريض قبل جرعة المضادات الحيوية مباشرةً، وكثيرًا ما ينصح الأطباء باستخدام الستيرويدات في علاج حالات التهاب السحايا عند الأطفال وذلك في حالة إصابتهم بعدوى المستدمية.
مضادات الفيروسات
في حالات التهاب السحايا الفيروسية يكون هنالك حاجة للاستعانة بمضادات الفيروسات لتقلل من آثار الإصابة وكذا يتم إعطاءها للمرافقين مع المريض لضمان عدم إصابتهم أو إيذائهم بأية عدوى، وهذه المضادات الفيروسية تسهم كثيرًا في تقليل أعراض ومضاعفات هذه الالتهابات؛ ولأن التهاب السحايا الفيروسي في الغالب لا يستجيب لنوع محدد من العلاج وخاصةً في حالة الإصابة بفيروس الحلأ البسيط والحلأ النطاقي فإنه يتوجب اختيار مضادات الفيروسات بعناية والتي في الغالب تكون الأسيكلوفير، ولكن السلبية الوحيدة في الأمر هي عدم وجود تجارب سريرية تثبت بدقة ما إذا كان العلاج فعالًا أم لا، بينما في حالات التهاب السحايا الفيروسية الطفيفة يتم معالجة المريض في المنزل مع الاستعانة ببعض السوائل والمسكنات وكذلك ملازمة الفراش.
مضادات الفطريات
عند الإصابة بالتهاب السحايا الفطري يتم اللجوء لبعض جرع شديدة من مضادات الفطريات ولكن يمتد ذلك لفترات طويلة ومن هذه المضادات الفطرية نجد الأمفوتريسين وفلوسيتوسين، ولأن التهاب السحايا الفطري معروف بتزامنه مع ارتفاع الضغط داخل الجمجمة بشكل كبير، فإنه يتم اللجوء لعملية البزل القطني وذلك بهدف تخفيف حدة الضغط بحيث تتم هذه العملية بشكل شبه يومي ومتكرر.
في معظم حالات التهاب السحايا البكتيري يتم بدايةً اللجوء للمضادات الحيوية سواءً بكتيرية أو فيروسية أو فطرية، كما يجب الاهتمام بضغط المريض والتأكد من انضباطه وانتظامه، وفي حالات انخفاض ضغط الدم أو تعرض المريض لصدمة ما فإنه يجب إعطاء المريض بعض السوائل عن طريق الوريد، وفي حالات أخرى عديدة تكون هنالك حاجة لأن يخضع المريض لأجهزة التنفس الصناعي وذلك عندما يلاحظ الطبيب انخفاض وعي المريض بشكل كبير أو ملاحظة أية دلائل عن الفشل التنفسي، وفي كل الحالات يجب الاهتمام بقياس ضغط الدم ومتابعته بشكل دوري لضمان الوصول إلى الضغط الأمثل للتروية الدماغية والعلاجات المختلفة وضمان تخفيف الضغط داخل الجمجمة بالاستعانة ببعض الأدوية مثل مانيتول، وفي حال تضاعف تأثير التهاب السحايا وحدوث نوبات صرع فإنه يجب إنقاذ المريض وإسعافه فورًا باستخدام مضادات الاختلاج، وفي الحالات الأخرى التي تصاب فيها الرأس بالمَوَه وهو انسداد تدفق السائل الدماغي الشوكي فإنه يتم اللجوء لإدخال جهاز صرف مؤقت أو طويل الأمد يعمل كتحويلة دماغية للسائل المتدفق.
أعراض التهاب السحايا البكتيري
ارتفاع درجة الحرارة
وتظهر بشكل مفاجئ حيث يسخن الجسم فجأة وتزداد حرارته بشكل ملفت للنظر دول أية أمراض واضحة إلا إذا كان قد تعرض للتصادم أو الكسر في الجمجمة، حينها فقط قد يستطيع المحيطين بالمريض توقع ما تعرض له.
صداع
والصداع في حالة التهاب السحايا البكتيري يتطور بمرور الوقت، بل إنه تم الكشف عن حالات صداع نصفي كانت سببًا في إصابة الدماغ بحالات التهاب السحايا البكتيري.
تيبس الرقبة
ويعتبر هذا العرَض أحد أبرز أعراض التهاب السحايا البكتيري، وفيه يعجز المريض عن تحريك رقبته ويعاني بآلام شديدة إذا حاول تحريكها عنوة.
دوخة وغثيان وقيء
وهو أمر بديهي لمن يتعرض لمعظم الأمراض الدماغية وأمراض المخ والأعصاب، إلا أنه عرَضٌ أكثر بروزًا وارتباطًا بحالات التهاب السحايا البكتيري.
تباين مستوى الوعي والإدراك
وفي هذه الحالة وبعد ظهور هذا العرَض تحديدًا تبدأ الظنون في مسايرة أهل المريض ويصيبهم الخوف والهلع على مريضهم وهنا قد تظهر للطبيب المختص أنها بدايات التهاب السحايا البكتيري.
التضرر من الجلوس في الإضاءة الشديدة
وقد يكون المريض من معتادي الجلوس في الإضاءة وأمام التلفاز وشاشات الكمبيوتر وغيرها، إلا أنه عند إصابته بالتهاب السحايا البكتيري ترفض عينيه تقبل ذلك ويبدأ المخ بإرسال إشارات للعين تمنعها عن المعايشة الطبيعية ضمن هذه الأضواء وذلك لأن الأعصاب الدماغية الموصلة بالعين تكون قد تضررت من فعل التهاب السحايا البكتيري.
حساسية الجلد
وتظهر حساسية الجلد هذه على هيئة بثور صغيرة بأشكال وأحجام مختلفة وبألوان أحمر وبنفسجي.
الإصابة بتشنجات
وهي أعراض متطورة ومتقدمة كثيرًا في الإصابة بالتهاب السحايا البكتيري وتكون مؤكدة للطبيب المختص بأن المريض بنسبة كبيرة يعاني من هذه الالتهابات.
في حالات متقدمة من الإصابة بالتهاب السحايا البكتيري قد تتأثر حواس الجسم من سمع وبصر ويبدأ المريض في فقد القدرة على استعمالهما؛ ولذلك ينصح بضرورة الكشف السريع على المريض بمجرد ملاحظة أي من الأعراض بالأعلى لأن التهاب السحايا البكتيري من الأمراض التي تتطور سريعًا وتظهر مضاعفاتها الخطرة خاصةً عندما ينتشر التهاب السحايا هذا في خلايا الدماغ بشكل كبير وقد يؤدي إلى الوفاة.
الفحوصات الطبية التي يخضع لها المريض
فحص الدم
في حالة ظهور أعراض الإصابة بالتهاب السحايا البكتيري يتعين على الطبيب المعالج طلب فحوصات عاجلة للدم لكشف أي خلل يثبت هذه الإصابة.
صورة طبقية للدماغ
يتم عمل أشعة دماغية تصور الدماغ بشكل واضح لتحدد خلايا المنطقة المحيطة بالدماغ وتثبت أو تنفي حالة التهاب السحايا البكتيري، وهذه الصورة في الغالب ما تظهر السائل النخاع وتوضح ما إذا كانت نسبته طبيعية أم لا ومدى تأثيره في الخلايا المجاورة.
البزل القطني
وبالطبع تفيد عملية البزل كثيرًا في فحص السائل النخاعي والتأكد من إصابته ببكتيريا أو فيروسات أو جراثيم أو طفيليات أو أية كائنات دقيقة أو مواد كيماوية مسببة لالتهاب السحايا من عدمه، مع الأخذ في الاعتبار أن عملية البزل القطني تلك تتم لحالات التهاب السحايا البكتيري بشكل يومي ومتكرر لضمان الحفاظ على الطبقة المحيطة بالدماغ آمنة دومًا طول فترة العلاج.
كما يجب على الطبيب المختص سؤال أهل المريض -إن لم يتيسر سؤال المريض نفسه- عن ما إذا تعرض المريض لأية صدمات في الدماغ حتى وإن فات عليها وقت قريب، وكذلك عند التثبت من إصابة المريض بالتهاب السحايا البكتيري يجب حث أهل المريض على توخي الحذر وعلى تناول العقاقير والمضادات الحيوية الواقية من العدوى؛ نظرًا لأن التهاب السحايا ينتقل في معظم الأحيان من شخص لآخر في حالات التهاب السحايا البكتيري والتهاب السحايا الفطري والتهاب السحايا الجرثومي والتهاب السحايا الفطري، ولذا يجب توخي الحذر واتخاذ كافة سبل الحرص لعدم انتشار المرض بين أفراد الأسرة والزائرين وفريق التمريض والتطبيب.
مراحل تطور التهاب السحايا البكتيري
يعتبر التهاب السحايا البكتيري من الأمراض القديمة والتي ورد ذكرها في عدد لا بأس بع من الموسوعات الطبية القديمة، للحد الذي وصفها “أبقراط” في كتابه، كما وصفها أحد الأطباء في عام 1768، ورغم ذلك فإنها أخذت تنتشر وتنتشر دون إيجاد علاج حازم يقضي عليها وتسببت كثيرًا في انتشار السل لمدة تتخطى مائة عام، كما أن التهاب السحايا البكتيرية كانت معروفة ما قبل عصر النهضة حيث تحدث عنها ابن سينا، وكان النمساوي “أنطون فايكسيلباوم” وهو عالم ومختص في دراسة الجراثيم قد أعلن في عام 1887 عن اكتشافه للعدوى البكتيرية ومدى تسببها في مرض التهاب السحايا البكتيري، وأبرز أول أدلته على ارتباط العدوى البكتيرية بهذا المرض عندما وصف البكتيريا السحائية، بينما منذ عام (1842-1922) جاء هاينريش كينك ليستخدم أسلوبًا جديدًا في البزل القطني بهدف توفير تحليل مبكر للسائل الدماغي.
وبمرور الوقت أخذ المرض ينتشر ويُعْرَف أكثر في العالم خاصةً عندما انتشرت أول عدوى كبرى في أفريقيا عام 1840 ما جعلها شهيرة للغاية وتعاظم اسمها وشهرتها في القرن العشرين عندما اجتاحت نيجيريا وغانا فيما بين عامَي 1905 – 1908 والتي تسببت في وفاة أعداد مهولة من المواطنين الأفارقة.
ملحوظة: هذا المقال يحتوي على نصائح طبية، برغم من أن هذه النصائح كتبت بواسطة أخصائيين وهي آمنة ولا ضرر من استخدامها بالنسبة لمعظم الأشخاص العاديين، إلا أنها لا تعتبر بديلاً عن نصائح طبيبك الشخصي. استخدمها على مسئوليتك الخاصة.



